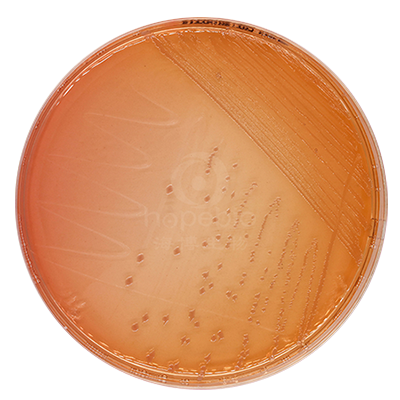
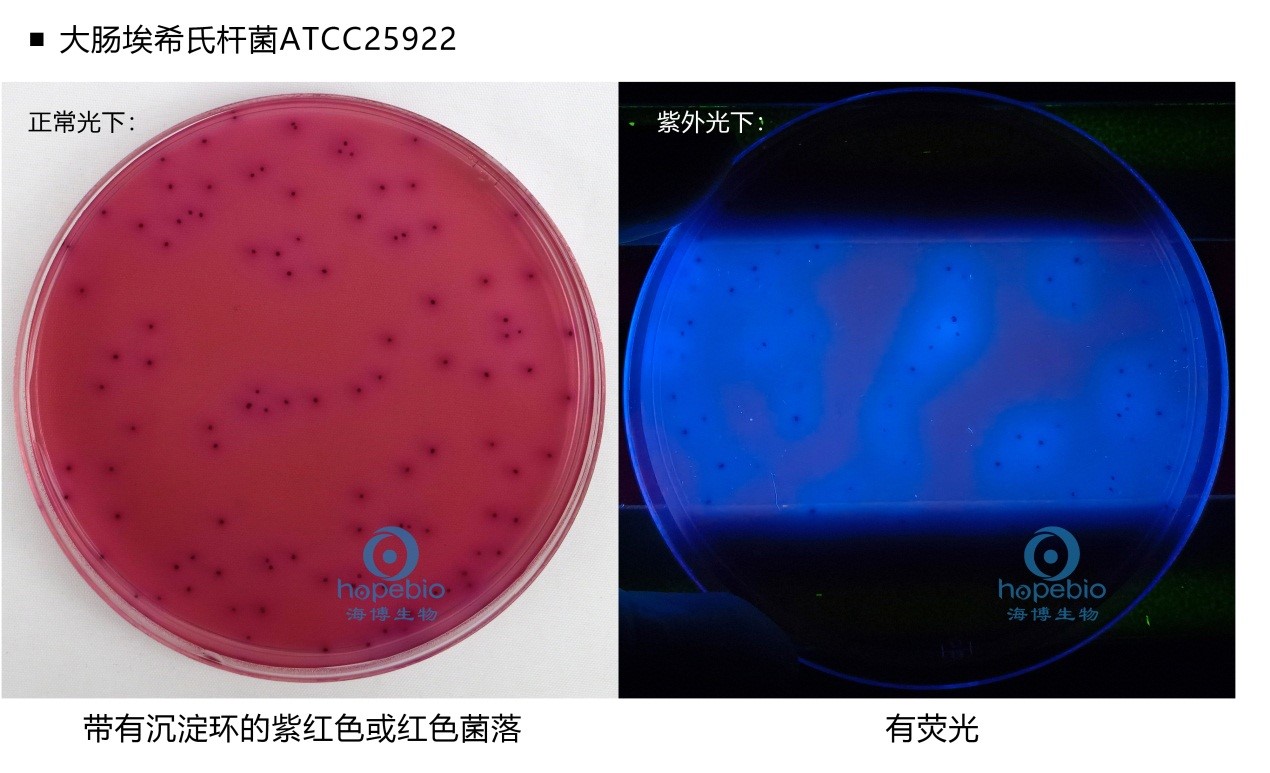
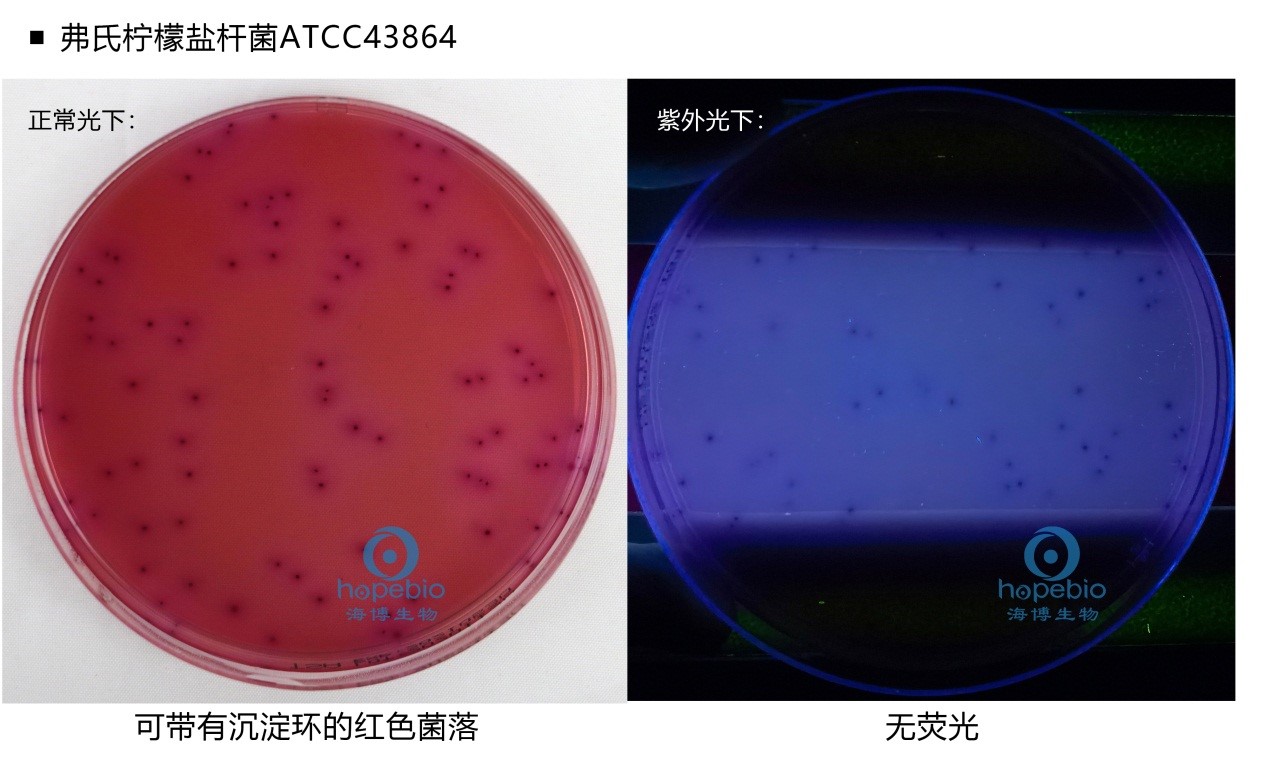

海博微信公众号
海博微信公众号
 海博天猫旗舰店
海博天猫旗舰店


 海博微信公众号
海博微信公众号
 海博天猫旗舰店
海博天猫旗舰店




大肠埃希氏菌(Escherichia coli)通常被称为大肠杆菌。其对营养要求不高且传代速率较快,具有完整的基因组序列信息和清楚的遗传学背景。目前广泛应用于微生物学的各个领域。
培养基作为细菌生长的温床,是细菌培养和传代的基础。大肠埃希氏菌在不同的培养基上也会产生不同的性状,依据这些性状,可以将部分菌种进行特异性识别,快速分辨出目标菌种。下面将从大肠埃希氏菌的分离和增菌两部分进行培养基介绍。
1. 大肠杆菌增菌培养基
在实验室环境中,我们经常需要从各种样品中分离得到单一的大肠埃希氏菌,这就需要培养基具有选择性,但是我们收到的样品可能常常面临着细菌活性受抑制,大肠埃希氏菌并非优势菌群等问题。有时我们也需要高纯度高浓度的大肠埃希氏菌菌液来获取其表达产物。这都需要我们对大肠埃希氏菌进行增菌培养。
成分:单位g/L
|
胰蛋白胨 |
17.0 |
|
大豆蛋白胨 |
3.0 |
|
氯化钠 |
5.0 |
|
磷酸氢二钾 |
2.5 |
|
葡萄糖 |
2.5 |
TSB是一种常见的非选择性增菌液体培养基,其含有丰富的营养物质。大肠杆菌可以在TSB中生长和繁殖。表现为培养基浑浊。

② LB肉汤
基因工程中常见的增菌培养基之一,在其中加入抗生素还可以特异性增菌有相关抗性基因表达的大肠埃希氏菌工程菌。
成分:单位g/L
|
胰蛋白胨 |
10.0 |
|
酵母浸粉 |
5.0 |
|
氯化钠 |
5.0 |

③ SOB培养基
SOB也是基因工程培养中常用的富营养培养基。与LB培养基相比,SOB培养基含有两倍的蛋白胨,能提供更丰富的营养。SOB中的镁离子也是进行高密度培养的必须的离子。利用SOB培养基增菌大肠杆菌,在摇瓶培养的条件下,可以达到很高的浓度值。
此外,基因工程中还常用到SOC、TB、SB、GYT、2x YT培养基等增菌培养基。其均所含丰富的营养,但用主要途不一,以不同比例的碳源,利用微生物利用碳源的优先级不同的原理,从而获得倾向不同的表达产物。

2.大肠埃希氏菌分离培养基
在日常的检测或培养中,我们经常需要从含杂菌的样品中分离获得可疑大肠埃希氏菌菌落进行确证试验。此时就需要使用到大肠埃希菌分离培养基。
① LB琼脂
在LB肉汤中加入琼脂(15g/L)即可在使培养基在冷却后凝固。在其中加入抗生素(如卡那霉素、氨苄青霉素)即可筛选对抗生素耐药的细菌,去除对抗生素不耐药的杂菌。通常,抗生素抗性基因是通过质粒所赋予的。例如加入卡那霉素后的LB琼脂平皿,普通的大肠埃希氏菌无法生长,而含有卡那霉素抗性基因的DH5α大肠埃希氏菌则可以生长。
EMB是一种弱选择性的培养基,主要用于分离肠道致病菌,尤其是大肠埃希氏菌。
成分:单位g/L
|
蛋白胨 |
10.0 |
|
乳糖 |
10.0 |
|
磷酸氢二钾 |
2.0 |
|
琼脂 |
15.0 |
|
伊红 |
0.4 |
|
美蓝 |
0.065 |
蛋白胨作为基础营养物质提供细菌生长所需的氮源以及其他营养元素;乳糖作为可发酵的碳源;伊红和美蓝同时作为抑制剂和指示剂,在酸性条件下产生沉淀,形成具黑色中心有金属光泽或无光泽的菌落。伊红为酸性染料,美蓝为碱性染料,细菌分解乳糖产酸时,细菌带正电荷,可以与带负电的酸性染料结合即染上了伊红的颜色;如果细菌因产碱性物质较多,带负电荷时与带正电荷的碱性染料美蓝结合而使得菌落呈蓝色。细菌产酸量较大时,染料可析出结晶形成金属光泽。磷酸氢二钾维持缓冲体系;琼脂作为凝固剂。
大肠埃希氏菌分解乳糖大量产酸,因此细菌菌落带正电荷染上红色,再与美蓝结合形成紫黑色菌落且带有金属光泽。产气肠杆菌产酸能力较大肠埃希氏菌弱,菌落呈棕色,很少有金属光泽。不分解乳糖的细菌,如沙门氏菌和志贺氏菌(宋内志贺氏菌迟缓分解乳糖),则为无色或半透明的菌落。金黄色葡萄球菌则被抑制或仅呈现针尖大小的菌落。

麦康凯琼脂常被缩写为MAC琼脂,是分离肠道菌最常见的琼脂。在药典中被用于大肠埃希氏菌的检测,而在国标中用于肠道致病菌的分离(应注意不同标准中的麦康凯琼脂成分并不完全一致)。
成分:g/L
|
蛋白胨 |
20.0 |
|
乳糖 |
10.0 |
|
牛胆盐 |
5.0 |
|
氯化钠 |
5.0 |
|
中性红 |
0.075 |
|
琼脂 |
12.0 |
培养基中含量较高的胆盐对大多数革兰氏阳性菌有很强的抑制效果。部分配方中还还有结晶紫,亦可加强对于革兰氏阳性菌的抑制效果。中性红在酸性条件下呈红色,碱性条件下呈橙黄色。大肠埃希氏菌强烈发酵乳糖产酸,因此在培养基上呈现桃红色菌落,并具有胆盐沉淀环。大肠菌群同样能发酵乳糖产酸,菌落呈桃红色。
沙门氏菌,志贺氏菌(除宋内志贺氏菌)等不发酵乳糖,因此菌落呈现无色,且培养过程中代谢产物氧化后PH会升高,平皿会呈现橙黄色。但MAC琼脂较难分别出大肠埃希氏菌和大肠菌群,因此应按相应标准的要求继续进行确证试验。
 |
|
|
麦康凯琼脂培养基 |
麦康凯琼脂 |
|
大肠埃希氏菌ATCC25922 |
福氏志贺氏菌CMCC(B)51572 |
大肠杆菌显色培养基是利用酶底物法,让大肠埃希氏菌在培养基上显示出独特颜色,与其他干扰菌区分开来,对于分离大肠埃希氏菌有高度的特异性。大肠埃希氏菌具有独特的β-葡萄糖醛酸苷酶,可以分解培养基中的显色底物,释放出呈色团,让大肠埃希氏菌落呈蓝色。显色培养基的分离效率要远远高于其他培养基,尤其当样品的干扰菌较多时。但是其价格也相应较高。
在此培养基中,其他菌落呈无色、白色或其他颜色,大多数革兰氏阳性菌不生长。但是有极少数的大肠埃希氏菌不具有β-葡萄糖醛酸苷酶(如肠出血性大肠埃希氏菌O157:H7)在此培养基上无法显色。

大肠杆菌ATCC25922与产气肠杆菌CMCC(B)45103在大肠杆菌显色培养基上的生长现象
⑤ 含MUG的培养基
大肠埃希氏菌具有β-葡萄糖醛酸苷酶,可以特异性分解MUG,被分解后产生荧光产物,在紫外灯下观察时会有荧光。常用的有VRBA-MUG(紫红胆盐MUG培养基),NA-MUG(营养琼脂MUG培养基),EC-MUG(含MUG的EC肉汤培养基),LST-MUG(含MUG的月桂基硫酸盐胰蛋白胨肉汤培养基)等。
但应注意,在使用含MUG的固体培养基时,因为荧光产物容易扩散到培养基内,应尽快观察结果。在含MUG的液体培养基中,培养时间太久,细菌产酸过多时同样会影响荧光效果。
大肠埃希氏菌ATCC25922在VRBA-MUG上的生长结果
弗氏柠檬酸杆菌ATCC43864在VRBA-MUG上的生长结果

EC-MUG培养基的生长结果

LST-MUG培养基的生长结果
在日常的实验中可选用的大肠埃希氏菌相关的培养基多种多样。经过多年的发展,培养基已经从最基础的天然培养基,到化学合成商用培养基,可以根据不同的需求增减营养或其它成分,他们具有不同的性能和侧重点。我们只有根据所需目的,依据的标准正确选用相应的培养基,才能获得最佳效果。
注:本文属海博生物原创,未经允许不得转载。
上一篇:生孢梭菌的活化、保存及使用
| 相关文章: | ||



